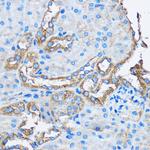
CAPZA2 Antibody in Immunohistochemistry (Paraffin) (IHC (P))

Search
Invitrogen
CAPZA2 Polyclonal Antibody
{{$productOrderCtrl.translations['antibody.pdp.commerceCard.promotion.promotions']}}
{{$productOrderCtrl.translations['antibody.pdp.commerceCard.promotion.viewpromo']}}
{{$productOrderCtrl.translations['antibody.pdp.commerceCard.promotion.promocode']}}: {{promo.promoCode}} {{promo.promoTitle}} {{promo.promoDescription}}. {{$productOrderCtrl.translations['antibody.pdp.commerceCard.promotion.learnmore']}}
图: 1 / 3
CAPZA2 Antibody (PA5-120748) in IHC (P)

Please note: We are reviewing Western blot images included in the antibody testing data in our catalog, including those provided by third parties. Unless expressly labeled or annotated as “raw-unedited”, Western blot images included in the antibody testing data in our catalog may have been edited, optimized or otherwise adjusted for presentation.
产品信息
PA5-120748
种属反应
宿主/亚型
分类
类型
抗原
偶联物
形式
浓度
规格
纯化类型
保存液
内含物
保存条件
运输条件
RRID
产品详细信息
Positive test controls include: HeLa, THP-1, 22Rv1, Mouse brain, Mouse heart.
Immunogen sequence: MADLEEQLSD EEKVRIAAKF IIHAPPGEFN EVFNDVRLLL NNDNLLREGA AHAFAQYNLD QFTPVKIEGY EDQVLITEHG DLGNGKFLDP KNRICFKFDH LRKEATDPRP CEVENAVESW RTSVETALRA YVKEHYPNGV CTVYGKKIDG QQTIIACIES HQFQAKNFWN GRWRSEWKFT ITPSTTQVVG ILKIQVHYYE DGNVQLVSHK DIQDSLTVSN EVQTAKEFIK IVEAAENEYQ TAISENYQTM SDTTFKALRR QLPVTRTKID WNKILSYKIG KEMQNA
靶标信息
The protein encoded by this gene is a member of the F-actin capping protein alpha subunit family. It is the alpha subunit of the barbed-end actin binding protein Cap Z. By capping the barbed end of actin filaments, Cap Z regulates the growth of the actin filaments at the barbed end.
仅用于科研。不用于诊断过程。未经明确授权不得转售。
篇参考文献 (0)
生物信息学
蛋白别名: capping protein alpha 2; CapZ alpha-2; CAZA2; F-actin-capping protein subunit alpha-2
基因别名: 1110053K06Rik; AW208808; Cappa2; CAPZA2
UniProt ID: (Mouse) P47754
Entrez Gene ID: (Mouse) 12343




